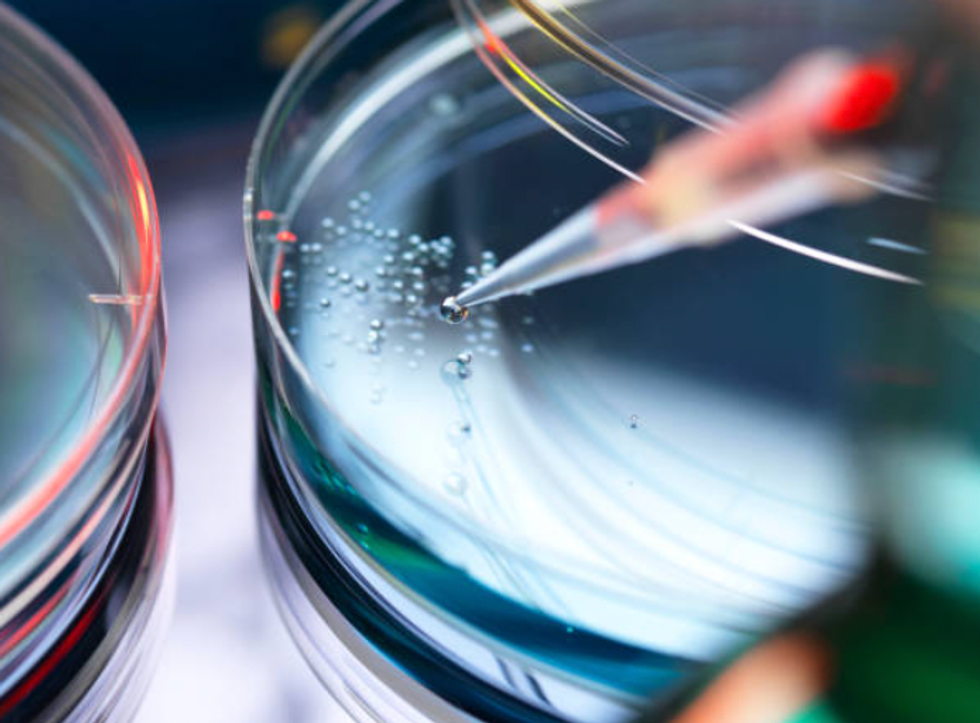
Stem cells

Want to reverse your body clock by 20 years? Longevity scientist claims to have found the simple answer

Boosting stem cell production can support the body’s natural ability to repair and stay healthy, scientist claims
|Christian Drapeau/Getty Images

Stem cells are being touted as the key to longevity. Our digital health editor Adam Chapman gets the low-down from a leading scientist in the field
Don't Miss
Most Read
Latest
Since the dawn of man, longevity has been the ultimate goal.
For centuries, praying to the gods was the only answer. Then science came online.
Fast forward to 2024 and researchers are pushing the limits of what is possible.
Stem cell production is the latest frontier in this exciting new field.
To understand more about the role that stems cells play in in the body and the promise they hold in extending human lifespan, GB News sat down with leading stem cell scientist Christian Drapeau.

Stem cells are known for their role in tissue repair
|Getty Images
Stem cells are essentially known for their role in tissue repair - they are the repair system of the body. But aside from this essential role, stem cells also play a vital role in tissue maintenance.
As the scientist explains, we experience “ageing” as a slow decline as we get older, but this is not how ageing is actually taking place in our tissues.
"During the entire life of an individual, cells are being lost in every single organ and tissue, and we stay healthy as long as we have enough stem cells in circulation to replace the cells that have been lost. All organs and tissues are constantly in a process of turnover," Drapeau explained.
The problem is that we are born with red marrow that makes stem cells, but it quickly converts into yellow marrow that does not make stem cells, he says.
By age 30 we have lost 90 percent of our red marrow, which corresponds to a 90 percent decline in the number of circulating stem cells.
"Ageing truly begins when we no longer have enough circulating stem cells to balance the natural process of tissue turnover," the scientist said.
He continued: "Over time, all age-related problems are caused by a deficit in stem cells; people with virtually any age-related disease have 50 percent or less than the number of circulating stem cells found in healthy people of the same age. We develop diseases because we can no longer effectively maintain our organs and tissues."
The solution? For Drapeau, it's all about "putting more stem cells in circulation every day gives back to the body its ability to repair as when we were 10 to 20 years younger, increasing quality of life and maintaining optimal health as we age".
That’s where Stemregen comes in. The scientist has created a blend of natural ingredients that he says helps the body release more of its own stem cells, assisting in the body’s natural repair and renewal system.
LATEST DEVELOPMENTS
"Taking two capsules will trigger the release of an average of 10 million additional stem cells from the bone marrow within two to three hours after consumption. Taking Stemregen daily supports the body’s natural ability to repair and stay healthy," he claimed.
Editor's take
The excitement in this field is understandable but it's important to manage expectations.
There's limited evidence to suggest that stem cell supplements can increase the body's stem cells.
More research is therefore needed to determine the effectiveness and safety of these products for various health conditions and general health purposes.
Stem cells have long shown considerable promise, however.
in 1999, Science named stem cell research at the very top of the 10 most important research fields in the 21st century.
And the field is only going from strength to strength.
For example, researchers have studied embryonic stem cell therapy in humans and animal models, including mice and rats.
Embryonic stem cell injections into mice with poor ovarian function improved ovarian function. A human study also showed that embryonic stem cells improved heart function following heart tissue injury.









